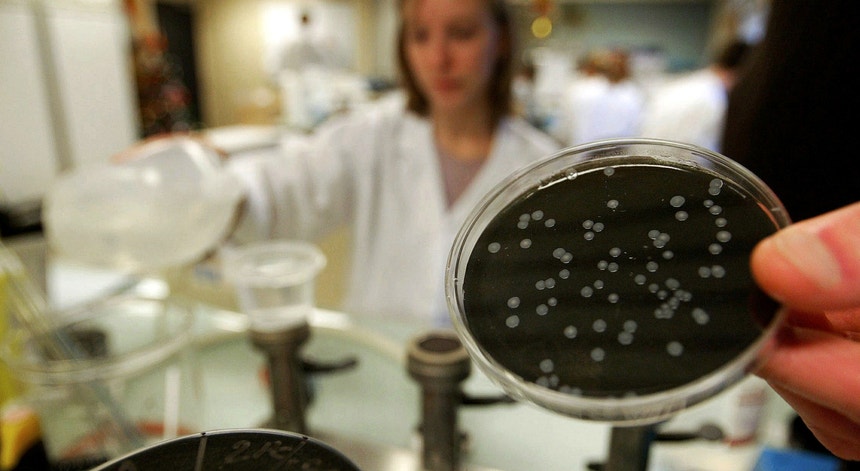

País
Saúde
DGS confirma dois casos mortais de legionella
A Direção-Geral da Saúde confirmou esta segunda-feira as mortes de duas pessoas infetadas com legionella. As vítimas estavam internadas no Hospital de Santa Maria e numa unidade privada de Lisboa.
Graça Freitas, diretora-geral da Saúde, confirmou ao final da tarde que o surto de legionella no hospital de São Francisco Xavier provocou dois óbitos: uma mulher de 70 anos que sofria de outros problemas de saúde e um homem de 77 que sofria também de várias comorbidades. As autoridades de saúde têm nesta altura registo de 29 casos.
“Uma pessoa que estava internada nos cuidados intensivos de Santa Maria, com 70 anos e várias comorbidades, e um senhor, com 77 anos, que estava internado numa unidade de cuidados intensivos de uma unidade privada de saúde”, explicou Graça Freitas.
Segundo a diretora-geral da Saúde, “em relação aos restantes casos verifica-se uma estabilização. Ao dia de hoje e até esta hora, foram notificados dois novos casos”.
Graça Freitas frisou que “no total estiveram doentes 29 pessoas, duas das quais morreram hoje”.
“Uma pessoa que estava internada nos cuidados intensivos de Santa Maria, com 70 anos e várias comorbidades, e um senhor, com 77 anos, que estava internado numa unidade de cuidados intensivos de uma unidade privada de saúde”, explicou Graça Freitas.
Segundo a diretora-geral da Saúde, “em relação aos restantes casos verifica-se uma estabilização. Ao dia de hoje e até esta hora, foram notificados dois novos casos”.
Graça Freitas frisou que “no total estiveram doentes 29 pessoas, duas das quais morreram hoje”.
Dos 29 infetados, "26 estão internados, três dos quais nos cuidados intensivos do Hospital São Francisco Xavier, onde foi detetada a infeção".
“A situação epidemiológica aponta para um declínio do número de casos que estão a ocorrer diariamente”, esclareceu.
“A situação epidemiológica aponta para um declínio do número de casos que estão a ocorrer diariamente”, esclareceu.
Origem do foco ainda não está esclarecida
A diretora-geral da Saúde, Graça Freitas, admitiu hoje que ainda não está esclarecida a origem do foco de infeção com a bactéria 'Legionella pneumophila' no hospital São Francisco Xavier.
"É prematuro dizer qual é o ponto de infeção", disse Graça Freitas em conferência de imprensa, insistindo em que não é ainda possível identificar uma origem específica da contaminação.
A diretora-geral da Saúde disse que os 29 casos diagnosticados até agora, na sua maioria idosos, eram tanto doentes que estavam a ser assistidos no hospital como acompanhantes que estiveram na zona das urgências e terão sido infetados pela bactéria "em vários locais diferentes", inclusivamente no exterior do edifício, o que, admitiu Graça Freitas, "pode ser compatível com as torres de refrigeração (de ar condicionado)" como fonte de contaminação.
As informações iniciais sobre o surto de infeção com legionella apontavam a canalização de água do hospital como origem da contaminação.
Graça Freitas disse hoje que logo que foi detetada a infeção "fez-se um tratamento de choque para interromper a contaminação".
As medidas tomadas incluíram "choque térmico, choque químico, purga nas águas e fecho das torres de refrigeração".
O Instituto Nacional de Saúde Ricardo Jorge recolheu análises em 11 pontos diferentes do Hospital São Francisco Xavier e demorará cerca de duas semanas até que haja resultados fiáveis.
"Para já é prematuro falar em falhas e tem que se dar tempo aos técnicos", disse hoje Graça Freitas, adiantando que "há uma expectativa positiva" para a evolução do surto, esperando-se que não continuem a surgir novos casos.
De acordo com Graça Freitas, a data da primeira contaminação terá sido 27 de outubro.
A diretora-geral da Saúde disse que os 29 casos diagnosticados até agora, na sua maioria idosos, eram tanto doentes que estavam a ser assistidos no hospital como acompanhantes que estiveram na zona das urgências e terão sido infetados pela bactéria "em vários locais diferentes", inclusivamente no exterior do edifício, o que, admitiu Graça Freitas, "pode ser compatível com as torres de refrigeração (de ar condicionado)" como fonte de contaminação.
As informações iniciais sobre o surto de infeção com legionella apontavam a canalização de água do hospital como origem da contaminação.
Graça Freitas disse hoje que logo que foi detetada a infeção "fez-se um tratamento de choque para interromper a contaminação".
As medidas tomadas incluíram "choque térmico, choque químico, purga nas águas e fecho das torres de refrigeração".
O Instituto Nacional de Saúde Ricardo Jorge recolheu análises em 11 pontos diferentes do Hospital São Francisco Xavier e demorará cerca de duas semanas até que haja resultados fiáveis.
"Para já é prematuro falar em falhas e tem que se dar tempo aos técnicos", disse hoje Graça Freitas, adiantando que "há uma expectativa positiva" para a evolução do surto, esperando-se que não continuem a surgir novos casos.
De acordo com Graça Freitas, a data da primeira contaminação terá sido 27 de outubro.
C/Lusa



